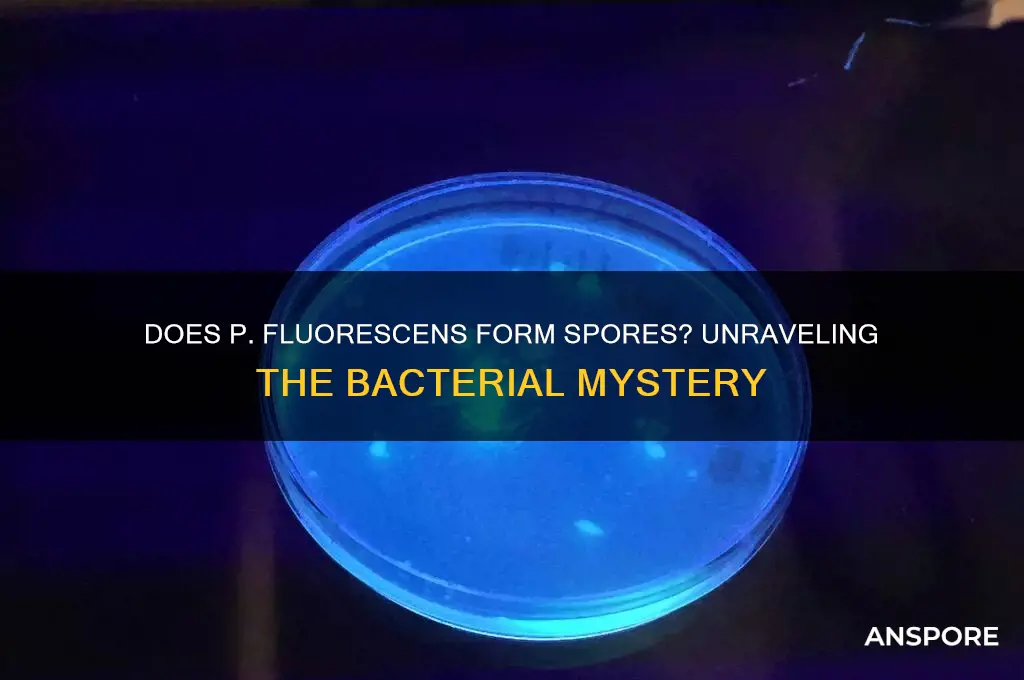
does p fluorescens form spore

*Pseudomonas fluorescens* is a Gram-negative, rod-shaped bacterium commonly found in soil, water, and plant surfaces, known for its diverse metabolic capabilities and biotechnological applications. One of the key questions regarding its biology is whether it forms spores, a dormant, highly resistant structure produced by some bacteria to survive harsh environmental conditions. Unlike spore-forming bacteria such as *Bacillus* or *Clostridium*, *P. fluorescens* does not produce spores under any known conditions. Instead, it relies on other survival strategies, such as biofilm formation and metabolic versatility, to endure adverse environments. This characteristic distinguishes it from spore-forming species and highlights its unique adaptations for persistence in diverse ecosystems.
Explore related products
What You'll Learn
- Spore Formation Mechanisms: Does P. fluorescens use specific genetic pathways for spore development
- Environmental Triggers: What conditions might induce P. fluorescens to form spores
- Comparative Analysis: How does P. fluorescens spore formation differ from other bacteria
- Survival Benefits: Do spores enhance P. fluorescens' resistance to stress or predators
- Laboratory Evidence: Are there confirmed studies showing P. fluorescens spore formation

Spore Formation Mechanisms: Does P. fluorescens use specific genetic pathways for spore development?
Pseudomonas fluorescens, a ubiquitous bacterium found in diverse environments, is known for its metabolic versatility and biocontrol capabilities. However, its ability to form spores remains a subject of debate. Unlike spore-forming bacteria such as Bacillus subtilis, which rely on well-characterized genetic pathways like the *spo0A* and *sigE* regulons, P. fluorescens lacks the canonical sporulation machinery. This absence raises questions about whether it employs alternative genetic mechanisms for spore-like structures or stress-resistant states. While some studies suggest P. fluorescens can form cyst-like structures under specific conditions, these are not true spores and lack the robust protective features of endospores.
Analyzing the genome of P. fluorescens reveals no homologs to key sporulation genes found in Bacillus or Clostridium species. For instance, the *spo0A* gene, a master regulator of sporulation in B. subtilis, is absent in P. fluorescens. Instead, P. fluorescens may utilize stress response pathways, such as those involving sigma factors like RpoS, to enhance survival under adverse conditions. These pathways, while not leading to spore formation, contribute to the bacterium's resilience by upregulating genes involved in osmotic protection, DNA repair, and nutrient scavenging.
From a practical standpoint, understanding whether P. fluorescens forms spores is crucial for its application in biocontrol and bioremediation. If true spores were produced, the bacterium could better withstand harsh conditions, such as desiccation or UV exposure, enhancing its efficacy in agricultural settings. However, the absence of sporulation pathways suggests that efforts to improve its survival should focus on optimizing growth conditions or engineering stress-tolerance mechanisms. For example, supplementing growth media with 0.5–1.0% glycerol can enhance osmotic stress resistance, while maintaining pH levels between 6.5 and 7.5 ensures optimal metabolic activity.
Comparatively, while P. fluorescens does not form spores, its close relative, Pseudomonas putida, also lacks sporulation capabilities but exhibits similar stress-resistant phenotypes. Both species rely on biofilm formation and exopolysaccharide production to protect against environmental stressors. This highlights a broader trend in non-spore-forming bacteria: the use of alternative strategies to achieve survival without true spore development. For researchers, this underscores the importance of studying species-specific adaptations rather than assuming universal mechanisms.
In conclusion, P. fluorescens does not utilize specific genetic pathways for spore development, relying instead on stress response and survival mechanisms. While this limits its ability to form true spores, it opens avenues for exploring how non-sporulating bacteria adapt to challenging environments. Practical applications, such as biocontrol, should focus on enhancing existing survival strategies rather than attempting to induce sporulation. This nuanced understanding of P. fluorescens’ biology ensures its effective use in real-world scenarios.
Eating Potatoes with Spores and Sweet Potatoes: Safe or Risky?
You may want to see also

Environmental Triggers: What conditions might induce P. fluorescens to form spores?
Observation: While *Pseudomonas fluorescens* is not traditionally known as a spore-forming bacterium, certain environmental stressors can push it toward adopting survival strategies akin to sporulation. Understanding these triggers is crucial for both ecological research and biotechnological applications.
Analytical Insight: Nutrient deprivation is a primary environmental trigger that could induce *P. fluorescens* to enter a dormant, spore-like state. When carbon sources such as glucose or amino acids drop below 0.1% (w/v) in its habitat, the bacterium may initiate metabolic shutdown. This response mimics sporulation in other species, allowing it to withstand harsh conditions like desiccation or extreme temperatures. Studies suggest that starvation-induced dormancy in *P. fluorescens* increases survival rates by up to 70% in soil environments over 6 months.
Instructive Guidance: To experimentally induce spore-like formation in *P. fluorescens*, researchers can simulate nutrient scarcity by culturing the bacterium in minimal media (e.g., M9 agar) supplemented with trace carbon sources (0.05% glucose). Gradually reducing nutrient availability over 48–72 hours while monitoring cell morphology under phase-contrast microscopy can reveal signs of dormancy, such as cell wall thickening or reduced metabolic activity. Pairing this with viability assays (e.g., LIVE/DEAD staining) confirms survival in the dormant state.
Comparative Perspective: Unlike *Bacillus subtilis*, which forms highly resistant endospores under similar stressors, *P. fluorescens* likely relies on biofilm formation or cyst-like structures as its primary survival mechanism. However, recent genetic studies suggest that overexpression of stress-response genes (e.g., *rpoS*) in *P. fluorescens* can enhance its tolerance to UV radiation and osmotic shock, potentially bridging the gap between non-sporulating and sporulating bacteria. This highlights the bacterium’s adaptability under environmental pressure.
Practical Takeaway: For agricultural applications, understanding these triggers can optimize *P. fluorescens* as a biocontrol agent. Applying it to soil during periods of low nutrient availability (e.g., late autumn or early spring) may enhance its survival and efficacy against plant pathogens. Pairing it with organic amendments like compost (rich in trace nutrients) can balance dormancy induction with metabolic activity, ensuring long-term colonization without compromising its protective role.
Vinegar's Power: Effective Mold Spores Cleaning Solution or Myth?
You may want to see also

Comparative Analysis: How does P. fluorescens spore formation differ from other bacteria?
Pseudomonas fluorescens, a ubiquitous bacterium found in diverse environments, does not form spores under typical conditions. This contrasts sharply with spore-forming bacteria like Bacillus subtilis and Clostridium botulinum, which produce highly resistant endospores as a survival strategy. While P. fluorescens lacks this ability, it employs alternative mechanisms to endure harsh conditions, such as biofilm formation and the production of protective exopolysaccharides. Understanding these differences is crucial for applications in biotechnology, agriculture, and environmental management, where P. fluorescens is often utilized for its biocontrol properties.
Analyzing the spore formation process reveals distinct structural and functional disparities. Spores of Bacillus species, for instance, are characterized by a multilayered structure, including a thick peptidoglycan cortex and a proteinaceous coat, which confer extreme resistance to heat, desiccation, and chemicals. In contrast, P. fluorescens relies on its robust metabolic versatility and rapid adaptation to environmental changes, rather than a dormant spore state. This highlights the evolutionary trade-off between investing energy in spore formation versus maintaining active metabolic pathways for survival.
From a practical standpoint, the absence of spore formation in P. fluorescens has implications for its use in industrial and agricultural settings. For example, in biocontrol applications, P. fluorescens must be applied under conditions that support its active growth, as it cannot persist in a dormant spore state. This necessitates careful consideration of factors like moisture, temperature, and nutrient availability. In contrast, spore-forming bacteria can be formulated into stable products, such as dried powders, which remain viable for extended periods. This difference underscores the need for tailored strategies when deploying P. fluorescens in field applications.
A comparative analysis also reveals differences in regulatory mechanisms. Spore formation in bacteria like Bacillus is tightly controlled by a network of genes, including the master regulator Spo0A, which responds to environmental stresses. P. fluorescens, however, lacks homologous sporulation pathways, instead relying on stress-responsive genes that activate protective mechanisms like efflux pumps and antioxidant systems. This divergence in genetic regulation reflects the distinct evolutionary trajectories of these bacteria, shaped by their ecological niches and survival strategies.
In conclusion, while P. fluorescens does not form spores, its survival mechanisms offer unique advantages and challenges compared to spore-forming bacteria. By focusing on its active metabolic capabilities and adaptive responses, researchers and practitioners can harness its potential effectively. This comparative analysis underscores the importance of understanding bacterial survival strategies in their broader ecological and applied contexts, guiding the development of innovative solutions in biotechnology and beyond.
Save Spore Creatures: Modding Tips for Preservation and Gameplay
You may want to see also
Explore related products

Survival Benefits: Do spores enhance P. fluorescens' resistance to stress or predators?
Pseudomonas fluorescens, a ubiquitous bacterium found in diverse environments, is known for its metabolic versatility and biocontrol potential. However, unlike spore-forming bacteria such as Bacillus subtilis, P. fluorescens does not produce spores under standard conditions. This raises a critical question: if P. fluorescens could form spores, would this enhance its resistance to environmental stressors or predation? To explore this, we must first understand the survival advantages spores confer to other bacteria and then extrapolate their potential impact on P. fluorescens.
Spores are metabolically dormant, highly resistant structures that protect bacteria from harsh conditions such as desiccation, extreme temperatures, and UV radiation. For instance, Bacillus spores can survive for decades in soil, reviving when conditions improve. If P. fluorescens were to form spores, it could theoretically extend its survival in adverse environments, such as nutrient-depleted soils or polluted water. This would be particularly beneficial in agricultural settings, where P. fluorescens is used as a biocontrol agent against plant pathogens. Sporulation could enable it to persist longer in the rhizosphere, enhancing its efficacy and reducing the need for frequent reapplication.
Predation by protozoa and bacteriophages is another significant threat to bacterial survival. Spores are less susceptible to predation due to their robust outer coat and dormant state, which makes them less attractive targets. For P. fluorescens, sporulation could serve as a defense mechanism against grazing by amoebae or infection by phages. However, this advantage would depend on the specific predators present in its environment. For example, certain predators have evolved mechanisms to detect and consume spores, which could limit the protective benefits.
While the hypothetical sporulation of P. fluorescens offers intriguing survival advantages, it is essential to consider the trade-offs. Sporulation is energetically costly and diverts resources from growth and reproduction. In nutrient-rich environments, such as plant roots, the benefits of sporulation might not outweigh the costs. Additionally, genetic engineering would likely be required to induce sporulation in P. fluorescens, raising ethical and regulatory concerns for its use in agriculture or biotechnology.
In conclusion, if P. fluorescens were capable of forming spores, it could significantly enhance its resistance to environmental stressors and predation. However, this adaptation would need to be balanced against the energetic costs and ecological context. For researchers and practitioners, exploring this possibility through synthetic biology could open new avenues for improving the resilience and application of P. fluorescens in various industries. Until then, understanding its current survival mechanisms remains crucial for optimizing its use in real-world scenarios.
Playing Spore Without the Disc: Is It Possible and How?
You may want to see also

Laboratory Evidence: Are there confirmed studies showing P. fluorescens spore formation?
Observation: Despite widespread interest in *Pseudomonas fluorescens* for its biocontrol and bioremediation applications, its ability to form spores remains a contentious topic. While some bacteria, like *Bacillus* spp., are well-known spore-formers, *P. fluorescens* is generally classified as non-sporulating. However, anecdotal reports and experimental anomalies have sparked curiosity about potential spore-like structures or dormant states under stress conditions.
Analytical Insight: Laboratory evidence on *P. fluorescens* spore formation is limited and often inconclusive. A 2003 study published in *Applied and Environmental Microbiology* investigated the bacterium’s response to desiccation stress, noting the formation of "spore-like cells" in a small subset of the population. However, these structures lacked the defining characteristics of true endospores, such as heat resistance and DNA encapsulation. Subsequent research has failed to replicate these findings consistently, suggesting that the observed structures may be artifactual or represent transient stress responses rather than true sporulation.
Instructive Guidance: For researchers seeking to explore this question, standardized protocols are essential. Culturing *P. fluorescens* under nutrient-limited or stress-inducing conditions (e.g., high salinity, low pH, or desiccation) may reveal morphological changes. Techniques like phase-contrast microscopy, electron microscopy, and staining for spore-specific markers (e.g., spore coat proteins) can help distinguish true spores from other cellular adaptations. However, caution is advised: misidentification of spore-like structures could lead to misinterpretation of results.
Comparative Perspective: Unlike *Bacillus subtilis*, which forms highly resistant endospores, *P. fluorescens* relies on other survival strategies, such as biofilm formation and metabolic versatility. While some *Pseudomonas* species (e.g., *P. aeruginosa*) have been shown to produce exospores under specific conditions, these are distinct from true endospores and lack their durability. This distinction underscores the importance of rigorous criteria when assessing spore formation in *P. fluorescens*.
Takeaway: Current laboratory evidence does not confirm *P. fluorescens* as a spore-forming bacterium. While occasional reports of spore-like structures exist, these lack reproducibility and fail to meet the criteria for true sporulation. Researchers should approach this topic with skepticism, focusing on well-controlled experiments and clear definitions of spore characteristics. Until definitive evidence emerges, *P. fluorescens* remains classified as non-sporulating, with its survival strategies centered on alternative mechanisms.
Mold Spores: Do They Float in Air or Settle on Surfaces?
You may want to see also
Frequently asked questions
No, *Pseudomonas fluorescens* is a non-spore-forming bacterium.
P. fluorescens lacks the genetic and physiological mechanisms required for spore formation, which is typical for bacteria in the *Pseudomonas* genus.
Yes, P. fluorescens can survive in harsh environments through other mechanisms, such as producing protective biofilms and stress-resistant cells.
No, none of the *Pseudomonas* species, including P. fluorescens, are known to form spores.






























